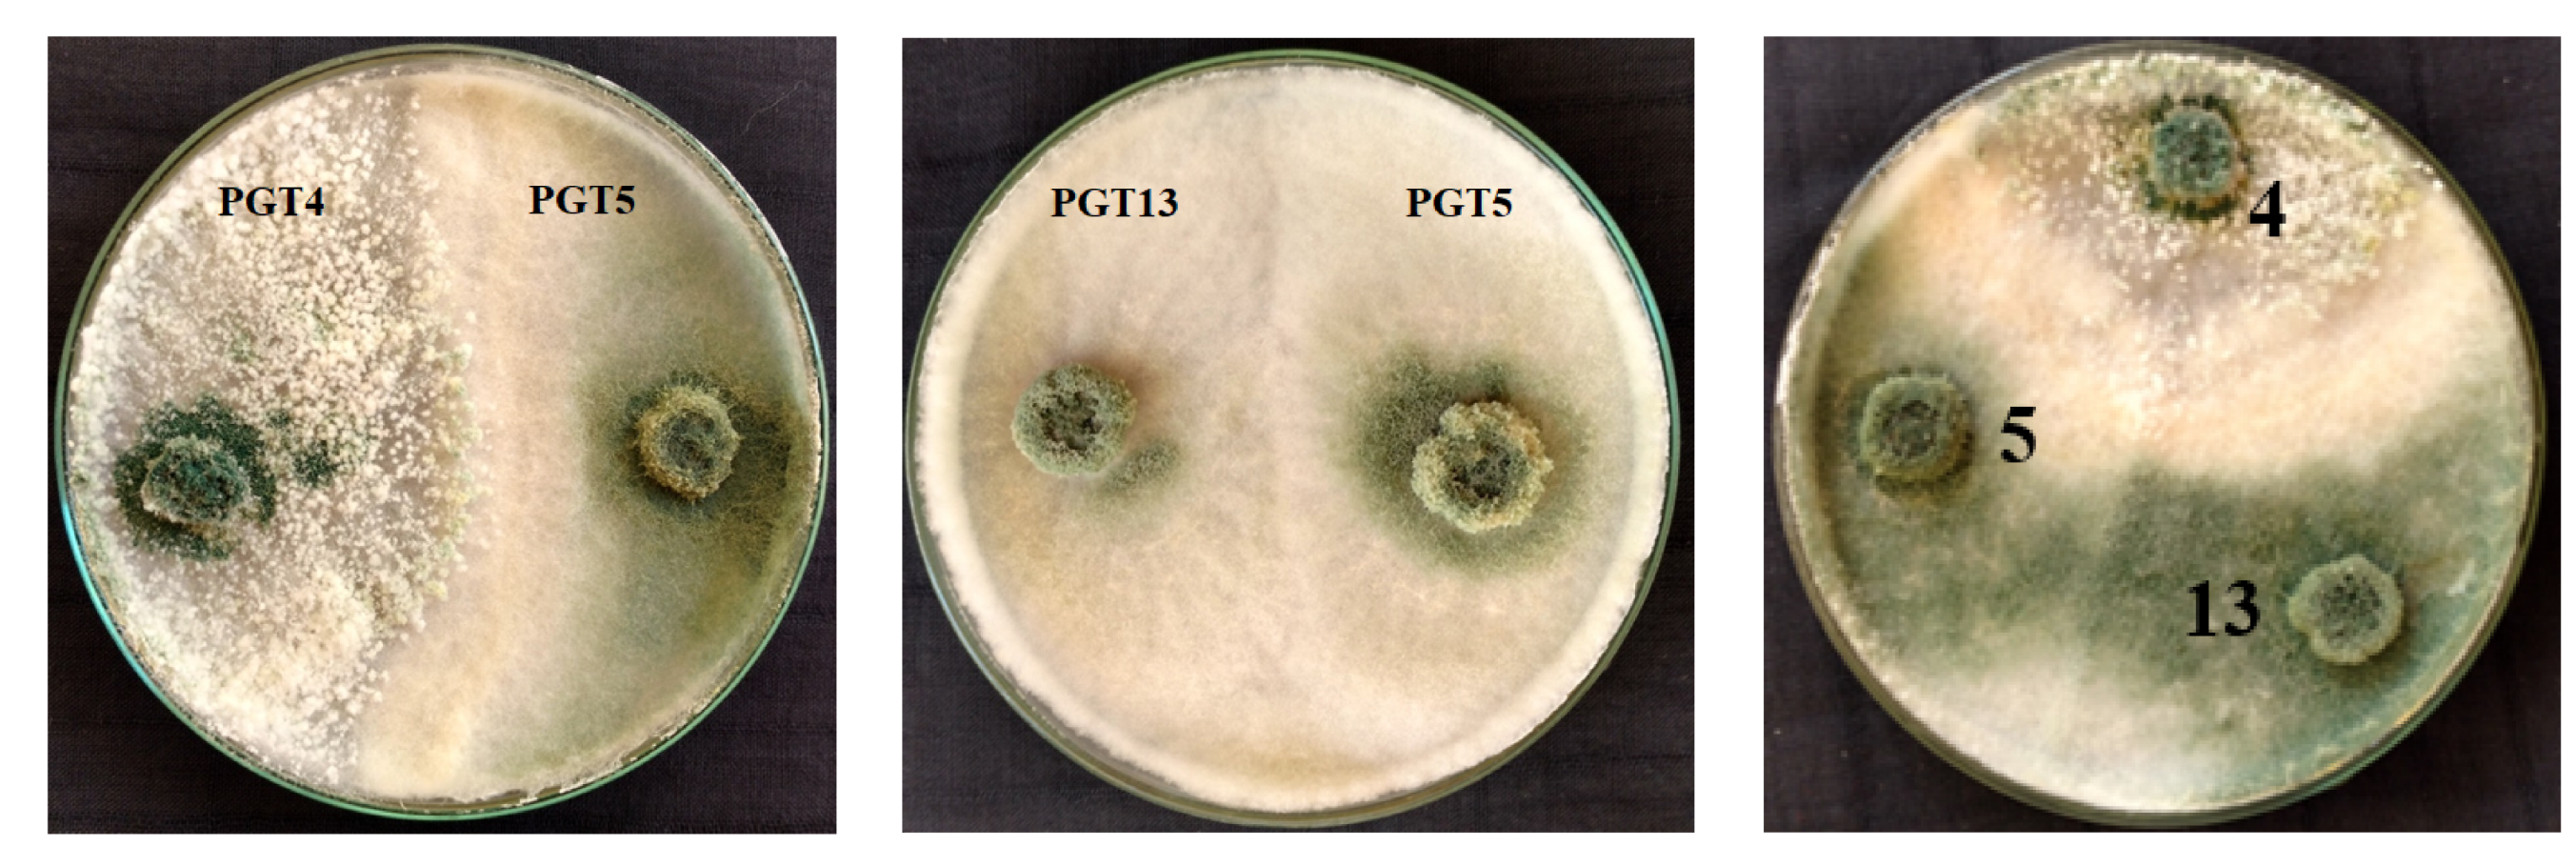
Jof 06 00181 g001
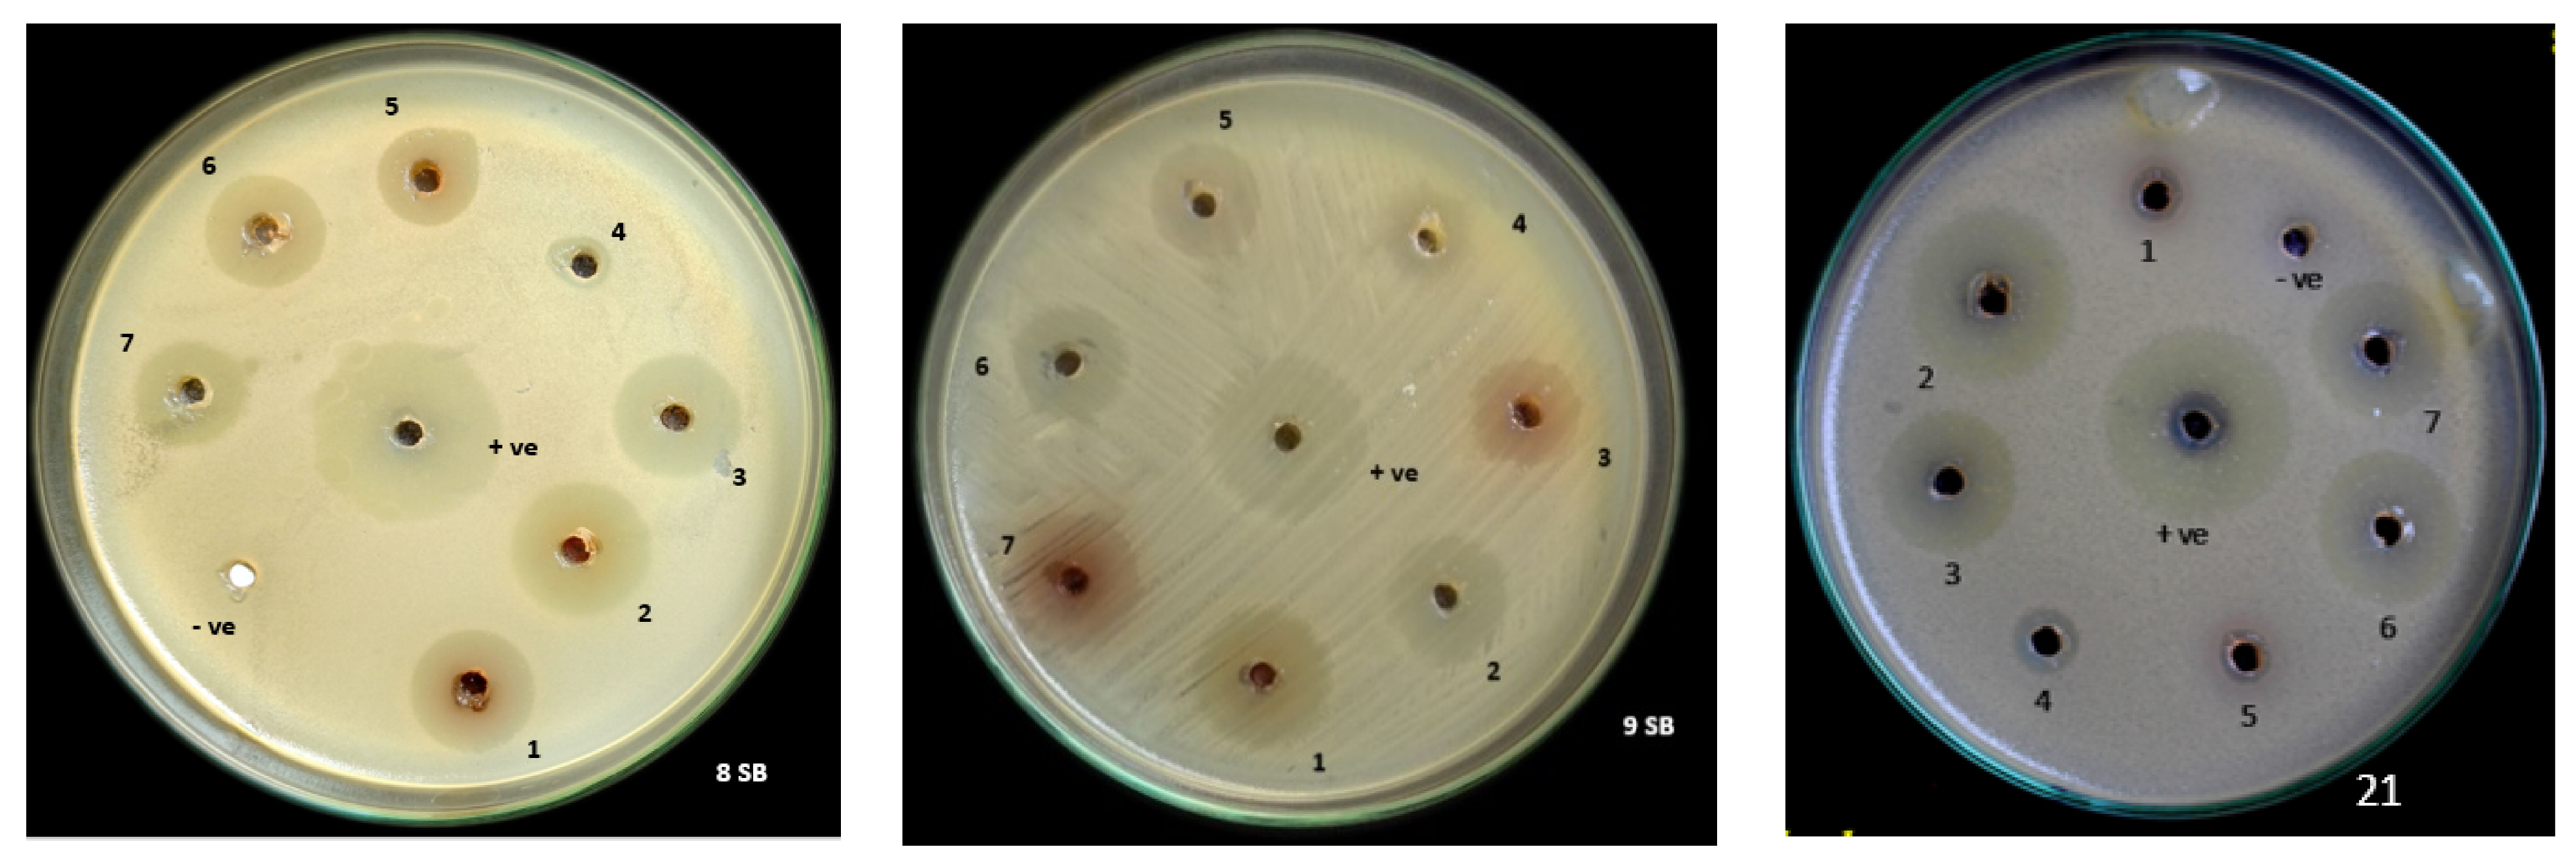
Jof 06 00181 g003

Mycosynthesis of ZnO Nanoparticles Using Trichoderma spp. Isolated from Rhizosphere Soils and Its Synergistic Antibacterial Effect against Xanthomonas oryzae pv. oryzae
Abstract
1. Introduction
2. Materials and Methods
2.1. Collection and Isolation of Bacteria from Infected Rice Leaf
2.2. Identification of Isolated Bacteria by Biochemical and Molecular Characterization
2.3. Collection and Isolation of Trichoderma spp. from Rhizosphere Soil
2.4. Morphological and Molecular Characterization of Trichoderma spp.
2.5. In Vitro Screening of Plant Growth-Promoting Fungi (PGPF) Strains of Trichoderma spp. for Its Antibacterial Activity by Agar Plug Method against Xanthomonas oryzae pv. oryzae (Xoo)
2.6. Trichoderma–Trichoderma Interactions through Co-Culture
2.7. Production of Secondary Metabolites from Trichoderma spp.
2.8. Extraction and Identification of Secondary Metabolites
2.9. In Vitro Screening of Secondary Metabolites Produced from Mono and Co-Culture of Trichoderma spp. for Its Antibacterial Activity by Agar Well Diffusion Method against Xanthomonas oryzae pv. oryzae (Xoo)
2.10. Mycoynthesis of Zinc Oxide Nanoparticles (ZnO NPs)
2.11. Characterization of Mycosynthesized Zinc Oxide Nanoparticles
2.12. Antibacterial Activity of Mycosynthesized ZnO NPs against Xanthomonas oryzae
2.13. Statistical Analysis
3. Results and Discussion
3.1. Collection and Isolation of Bacteria from Diseased Rice Leaf
3.2. Identification of Isolated Bacteria by Biochemical and Molecular Characterization
3.3. Collection of Rhizospheric Soil Samples
3.4. Isolation and Identification of Selected Trichoderma spp. by Molecular Characterization
3.5. In Vitro Screening of PGP Strains of Trichoderma spp. for Its Antibacterial Activity by Agar Plug Method against Xanthomonas oryzae pv. oryzae (Xoo)
3.6. Trichoderma–Trichoderma Interactions through Co-Culture
3.7. Identification of Secondary Metabolite Compounds by GC-MS Analysis
3.8. In Vitro Screening of PGPR Trichoderma spp. Co-Culture Secondary Metabolites for Its Antibacterial Activity by Agar Well Diffusion Method against Xanthomonas oryzae pv. oryzae (Xoo)
3.9. Characterization of Synthesized Nanoparticles
3.10. Antibacterial Activity
4. Conclusions
Supplementary Materials
Author Contributions
Funding
Conflicts of Interest
References
- Szareski, V.J.; Carvalho, I.R.; da Rosa, T.C.; Dellagostin, S.M.; de Pelegrin, A.J.; Barbosa, M.H.; Aumonde, T.Z. Oryza Wild Species: An alternative for rice breeding under abiotic stress conditions. Am. J. Plant Sci. 2018, 9, 1093. [Google Scholar] [CrossRef]
- Seck, P.A.; Diagne, A.; Mohanty, S.; & Wopereis, M.C. Crops that feed the world 7: Rice. Food Sec. 2012, 4, 7–24. [Google Scholar] [CrossRef]
- Latif, M.A.; Badsha, M.A.; Tajul, M.I.; Kabir, M.S.; Rafii, M.Y.; Mia, M.A.T. Identification of genotypes resistant to blast, bacterial leaf blight, sheath blight and tungro and efficacy of seed treating fungicides against blast disease of rice. Sci. Res. Essays 2011, 6, 2804–2811. [Google Scholar]
- Banerjee, A.; Roy, S.; Bag, M.K.; Bhagat, S.; Kar, M.K.; Mandal, N.P.; Maiti, D. A survey of bacterial blight (Xanthomonas oryzae pv. oryzae) resistance in rice germplasm from eastern and northeastern India using molecular markers. J. Crop Prot. 2018, 112, 168–176. [Google Scholar] [CrossRef]
- Jonit, N.Q.; Low, Y.C.; Tan, G.H. Xanthomonas oryzae pv. oryzae, Biochemical Tests, Rice (Oryza sativa), Bacterial Leaf Blight (BLB) Disease, Sekinchan. Appl. Environ. Microbiol. 2016, 4, 63–69. [Google Scholar]
- Hoque, M.E.; Mansfield, J.W.; Bennett, M.H. Agrobacterium-mediated transformation of Indica rice genotypes: An assessment of factors affecting the transformation efficiency. Plant Cell Tiss. Org. 2005, 82, 45–55. [Google Scholar] [CrossRef]
- Chukwu, S.C.; Rafii, M.Y.; Ramlee, S.I.; Ismail, S.I.; Hasan, M.M.; Oladosu, Y.A.; Olalekan, K.K. Bacterial leaf blight resistance in rice: A review of conventional breeding to molecular approach. Mol. Biol. Rep. 2019, 46, 1519–1532. [Google Scholar] [CrossRef]
- Naqvi, S.A.H.; Umar, U.D.; Hasnain, A.; Rehman, A.; Perveen, R. Effect of botanical extracts: A potential biocontrol agent for Xanthomonas oryzae pv. oryzae, causing bacterial leaf blight disease of rice. Pak. J. Agric. Sci. 2018, 32, 59–72. [Google Scholar] [CrossRef]
- Nasir, M.; Iqbal, B.; Hussain, M.; Mustafa, A.; Ayub, M. Chemical Management Of Bacterial Leaf Blight Disease In Rice. J. Agric. Res. 2019, 57, 99–103. [Google Scholar]
- Gnanamanickam, S.S.; Priyadarisini, V.B.; Narayanan, N.N.; Vasudevan, P.; Kavitha, S. An overview of bacterial blight disease of rice and strategies for its management. Curr. Sci. 1999, 1435–1444. [Google Scholar]
- Sattari, S.Z.; Van Ittersum, M.K.; Bouwman, A.F.; Smit, A.L.; Janssen, B.H. Crop yield response to soil fertility and N, P, K inputs in different environments: Testing and improving the QUEFTS model. Field Crops Res. 2014, 157, 35–46. [Google Scholar] [CrossRef]
- Naqvi, S.A.H. Bacterial leaf blight of rice: An overview of epidemiology and management with special reference to Indian sub-continent. Pak. J. Agric. Sci. 2019, 32, 359. [Google Scholar] [CrossRef]
- Kohl, J.; Kolnaar, R.; Ravensberg, W.J. Mode of action of microbial biological control agents against plant diseases: Relevance beyond efficacy. Front. Plant Sci. 2019, 10, 845. [Google Scholar] [CrossRef] [PubMed]
- Shyamala, L.; Sivakumaar, P.K. Integrated control of blast disease of rice using the antagonistic Rhizobacteria Pseudomonas fluorescens and the resistance inducing chemical salicylic acid. Int. J. Res. Pure Appl. Microbiol. 2012, 2, 59–63. [Google Scholar]
- Zhang, S.; Gan, Y.; Xu, B. Application of plant-growth-promoting fungi Trichoderma longibrachiatum T6 enhances tolerance of wheat to salt stress through improvement of antioxidative defense system and gene expression. Front. Plant Sci. 2016, 7, 1405. [Google Scholar] [CrossRef]
- Tariq, M.; Noman, M.; Ahmed, T.; Hameed, A.; Manzoor, N.; Zafar, M. Antagonistic features displayed by plant growth promoting rhizobacteria (PGPR): A review. J. Plant Sci. Phytopathol. 2017, 1, 38–43. [Google Scholar]
- Nurfalah, A.; Ayuningrum, N.; Affandi, M.R.; Hastuti, L.D.S. Promoting Growth of Tomato (Solanum lycopersicum L.) by using Trichoderma—Compost—Rice Bran based Biofertilizer. In Proceedings of the IOP Conference Series: Earth and Environmental Science, Medan, Indonesia, 8–9 December 2018; 2019; IOP Publishing: Bristol, UK; p. 012074. [Google Scholar]
- Lee, S.; Yap, M.; Behringer, G.; Hung, R.; Bennett, J.W. Volatile organic compounds emitted by Trichoderma species mediate plant growth. Fungal Biol. Biotechnol. 2016, 3, 7. [Google Scholar] [CrossRef]
- Prasad, R.; Kumar, M.; Varma, A. Role of PGPR in soil fertility and plant health. In Plant-Growth-Promoting Rhizobacteria (PGPR) and Medicinal Plants; Springer: Cham, Germany, 2015; pp. 247–260. [Google Scholar]
- Rahman, A.; Korejo, F.; Sultana, V.; Ara, J.; Ehteshamulhaque-Haque, S. Induction of systemic resistance in cotton by the plant growth promoting rhizobacterium and seaweed against charcoal rot disease. Pak. J. Bot. 2017, 49, 347–353. [Google Scholar]
- Gouda, S.; Kerry, R.G.; Das, G.; Paramithiotis, S.; Shin, H.S.; Patra, J.K. Revitalization of plant growth promoting rhizobacteria for sustainable development in agriculture. Microbiol. Res. 2018, 206, 131–140. [Google Scholar] [CrossRef]
- Vinale, F.; Nicolett, R.; Borrelli, F.; Mangoni, A.; Parisi, O.A.; Marra, R.; Lorito, M. Co-Culture of Plant Beneficial Microbes as Source of Bioactive Metabolites. Sci. Rep. 2017, 7, 14330. [Google Scholar] [CrossRef]
- Guilger, M.; Pasquoto-Stigliani, T.; Bilesky-Jose, N.; Grillo, R.; Abhilash, P.C.; Fraceto, L.F.; De Lima, R. Biogenic silver nanoparticles based on Trichoderma harzianum: Synthesis, characterization, toxicity evaluation and biological activity. Sci. Rep. 2017, 7, 44421. [Google Scholar] [CrossRef] [PubMed]
- Sun, K.G.; Hur, S.H. Highly sensitive non-enzymatic glucose sensor based on Pt nanoparticle decorated graphene oxide hydrogel. Sens. Actuators B Chem. 2015, 210, 618–623. [Google Scholar]
- Mazhar, T.; Shrivastava, V.; Tomar, R.S. Green synthesis of bimetallic nanoparticles and its applications: A review. J. Pharm. Sci. Res. 2017, 9, 102. [Google Scholar]
- Zare, E.; Pourseyedi, S.; Khatami, M.; Darezereshki, E. Simple biosynthesis of zinc oxide nanoparticles using nature’s source, and it’s in vitro bio-activity. J. Mol. Struct. 2017, 1146, 96–103. [Google Scholar] [CrossRef]
- El Sayed, M.T.; El-Sayed, A.S. Tolerance and mycoremediation of silver ions by Fusarium solani. Heliyon 2020, 6, e03866. [Google Scholar] [CrossRef]
- Iravani, S.; Varma, R.S. Greener synthesis of lignin nanoparticles and their applications. Green Chem. 2020, 22, 612–636. [Google Scholar] [CrossRef]
- Zheng, K.; Setyawati, M.I.; Leong, D.T.; Xie, J. Antimicrobial silver nanomaterials. Coord. Chem. Rev. 2018, 357, 1–17. [Google Scholar] [CrossRef]
- Lakshmeesha, T.R.; Sateesh, M.K.; Prasad, B.D.; Sharma, S.C.; Kavyashree, D.; Chandrasekhar, M.; Nagabhushana, H. Reactivity of crystalline ZnO superstructures against fungi and bacterial pathogens: Synthesized using Nerium oleander leaf extract. Cryst. Growth Des. 2014, 14, 4068–4079. [Google Scholar] [CrossRef]
- Lahuf, A.A.; Kareem, A.A.; Al-Sweedi, T.M.; Alfarttoosi, H.A. Evaluation the potential of indigenous biocontrol agent Trichoderma harzianum and its interactive effect with nanosized ZnO particles against the sunflower damping-off pathogen, Rhizoctonia solani. In Proceedings of the IOP Conference Series: Earth and Environmental Science, Banda Aceh, Indonesia, 21–21 August 2019; 2019; Volume 365, IOP Publishing: Bristol, UK; p. 012033. [Google Scholar]
- Chavali, M.S.; Nikolova, M.P. Metal oxide nanoparticles and their applications in nanotechnology. SN App. Sci. 2019, 1, 607. [Google Scholar] [CrossRef]
- Jabeen, R.; Iftikhar, T.; Batool, H. Isolation, characterization, preservation and pathogenicity test of Xanthomonas oryzae pv. oryzae causing BLB disease in rice. Pak. J. Bot. 2012, 44, 261–265. [Google Scholar]
- Garrity, G.M. Bergey’s manual of Systematic bacteriology. The Proteobacteria, 2nd ed.; In Bergey’s Manual Trust; Department of Microbiology and Molecular Genetics: East Lansing, MI, USA, 2005. [Google Scholar]
- Sandhu, A.F.; Khan, J.A.; Ali, S.; Arshad, H.I.; Saleem, K. Molecular Characterization of Xanthomonas oryzae pv. oryzae Isolates and its Resistance Sources in Rice Germplasm. PSM Microbiol. 2018, 3, 55–61. [Google Scholar]
- Goswami, D.; Dhandhukia, P.; Patel, P.; Thakker, J.N. Screening of PGPR from saline desert of Kutch: Growth promotion in Arachis hypogea by Bacillus licheniformis A2. Microbiol. Res. 2014, 169, 66–75. [Google Scholar] [CrossRef] [PubMed]
- Ru, Z.; Di, W. Trichoderma spp. from rhizosphere soil and their antagonism against Fusarium sambucinum. Afr. J. Biotechnol. 2012, 11, 4180–4186. [Google Scholar]
- Barnett, H.L.; Hunter, B.B. Illustrated Genera of Imperfect Fungi; APS Press: St. Paul, MN, USA, 1998; p. 218. [Google Scholar]
- Shahid, M.; Singh, A.; Srivastava, M.; Rastogi, S.; Pathak, N. Sequencing of 28SrRNA gene for identification of Trichoderma longibrachiatum 28CP/7444 species in soil sample. Int. J. Biotechnol. Wellness Ind. 2013, 2, 84–90. [Google Scholar] [CrossRef]
- Santos, I.P.D.; Silva, L.C.N.D.; Silva, M.V.D.; Araújo, J.M.D.; Cavalcanti, M.D.S.; Lima, V.L.D.M. Antibacterial activity of endophytic fungi from leaves of Indigofera suffruticosa Miller (Fabaceae). Front. Microbiol. 2015, 6, 350. [Google Scholar] [CrossRef]
- Ortuno, N.; Castillo, J.A.; Miranda, C.; Claros, M.; Soto, X. The use of secondary metabolites extracted from Trichoderma for plant growth promotion in the Andean highlands. Renew. Agr. Food Syst. 2017, 32, 366–375. [Google Scholar] [CrossRef]
- Vinale, F.; Nicoletti, R.; Lacatena, F.; Marra, R.; Sacco, A.; Lombardi, N.; Woo, S.L. Secondary metabolites from the endophytic fungus Talaromyces pinophilus. Nat. Prod. Res. 2017, 31, 1778–1785. [Google Scholar] [CrossRef]
- Dubey, S.C.; Tripathi, A.; Dureja, P.; Grover, A. Characterization of secondary metabolites and enzymes produced by Trichoderma species and their efficacy against plant pathogenic fungi. Indian J. Agric. Sci. 2011, 81, 455–461. [Google Scholar]
- Irshad, S.; Mahmood, M.; Perveen, F. In vitro antibacterial activities of three medicinal plants using agar well diffusion method. Res. J. Biol. Sci. 2012, 2, 1–8. [Google Scholar]
- Shelar, G.B.; Chavan, A.M. Myco-synthesis of silver nanoparticles from Trichoderma harzianum and its impact on germination status of oil seed. Biolife 2015, 3, 109–113. [Google Scholar]
- Nayak, S.; Bhat, M.P.; Udayashankar, A.C.; Lakshmeesha, T.R.; Geetha, N.; Jogaiah, S. Biosynthesis and characterization of Dillenia indica-mediated silver nanoparticles and their biological activity. Appl. Organomet. Chem. 2020, 34, e5567. [Google Scholar] [CrossRef]
- Mohammed, H.A.; Al Fadhil, A.O. Antibacterial activity of Azadirachta indica (Neem) leaf extract against bacterial pathogens in Sudan. Afr. J. Med.Sci. 2017, 3, 246–2512. [Google Scholar]
- Arshad, H.M.I.; Naureen, S.; Saleem, K.; Ali, S.; Jabeen, T.; Babar, M.M. Morphological and biochemical characterization of Xanthomonas oryzae pv. oryzae isolates collected from Punjab during 2013. Adv. Life Sci. 2015, 2, 125–130. [Google Scholar]
- Hermosa, R.; Viterbo, A.; Chet, I.; Monte, E. Plant-beneficial effects of Trichoderma and of its genes. Microbiology 2012, 158, 17–25. [Google Scholar] [CrossRef] [PubMed]
- Leelavathi, M.S.; Vani, L.; Reena, P. Antimicrobial activity of Trichoderma harzianum against bacteria and fungi. Int. J. Curr. Microbiol. Appl. Sci. 2014, 3, 96–103. [Google Scholar]
- Siddiquee, S.; Cheong, B.E.; Taslima, K.; Kausar, H.; Hasan, M.M. Separation and identification of volatile compounds from liquid cultures of Trichoderma harzianum by GC-MS using three different capillary columns. J. Chromatogr. Sci. 2012, 50, 358–367. [Google Scholar] [CrossRef] [PubMed]
- Ogunyemi, S.O.; Abdallah, Y.; Zhang, M.; Fouad, H.; Hong, X.; Ibrahim, E.; Li, B. Green synthesis of zinc oxide nanoparticles using different plant extracts and their antibacterial activity against Xanthomonas oryzae pv. oryzae. Artif. Cells Nanomed. Biotechnol. 2019, 47, 341–352. [Google Scholar] [CrossRef]
- Dobrucka, R.; Długaszewska, J. Biosynthesis and antibacterial activity of ZnO nanoparticles using Trifolium pratense flower extract. Saudi J. Biol. Sci. 2016, 23, 517–523. [Google Scholar] [CrossRef]
- Murali, M.; Mahendra, C.; Rajashekar, N.; Sudarshana, M.S.; Raveesha, K.A.; Amruthesh, K.N. Antibacterial and antioxidant properties of biosynthesized zinc oxide nanoparticles from Ceropegia candelabrum L.—an endemic species. Spectrochim. Acta A Mol. Biomol. Spectrosc. 2017, 179, 104–109. [Google Scholar] [CrossRef]
- Prasad, K.S.; Pathak, D.; Patel, A.; Dalwadi, P.; Prasad, R.; Patel, P.; Selvaraj, K. Biogenic synthesis of silver nanoparticles using Nicotiana tobaccum leaf extract and study of their antibacterial effect. Afr. J. Biotechnol. 2011, 10, 8122–8130. [Google Scholar]

| Trichoderma spp. Culture | Xoo Isolates (Zone of Inhibition) | ||
|---|---|---|---|
| MBXoo69 (mm in Diameter) | MBXoo70 (mm in Diameter) | MBXoo53 (mm in Diameter) | |
| PGT1 | 20.33 mno ± 0.577 | 22.33 qrs ± 0.577 | 19.33 lmn ± 1.155 |
| PGT2 | 19.67 lmn ± 0.577 | 21.00 mno ± 1.732 | 19.33 mno ± 1.155 |
| PGT3 | 20.00 mnop ± 0.000 | 20.33 lmn ± 1.528 | 19.00 lmn ± 1.000 |
| PGT4 | 18.33 jk ± 0.577 | 22.67 pqr ± 1.155 | 24.67 v ± 0.577 |
| PGT5 | 19.67 lmn ± 0.577 | 22.00 pq ± 1.000 | 19.67 lmn ± 0.577 |
| PGT6 | 19.33 lmn ± 0.577 | 21.33 pq ± 0.577 | 21.33 pqr ± 0.577 |
| PGT7 | 19.67 lmn ± 0.577 | 19. 67 lmn ± 0.577 | 20.33 mno ± 0.577 |
| PGT8 | 19.67 lmn ± 0.577 | 19.67 lmn ± 0.577 | 19.67 lmn ± 0.577 |
| PGT9 | 19.67 lmn ± 0.577 | 19.67 lmn ± 0.577 | 20.00 mno ± 0.000 |
| PGT10 | 19.67 lmn ± 0.577 | 17.67 ijk ± 0.577 | 19.67 lmn ± 0.577 |
| PGT11 | 19.67 lmn ± 0.577 | 21.33 pq ± 0.577 | 19.67 lmn ± 0.577 |
| PGT12 | 19.67 lmn ± 0.577 | 16.67 gh ± 0.577 | 20.00 mno ± 0.000 |
| PGT13 | 20.00 mno ± 0.000 | 21.67 pqr ± 0.577 | 19.67 lmn ± 0.577 |
| PGT14 | 19.67 lmn ± 0.577 | 21.67 pqr ± 0.577 | 19.67 lmn ± 0.577 |
| PGT15 | 16.00 fg ± 0.000 | 18.33 jk ± 0.577 | 20.00 mno ± 0.000 |
| PGT16 | 17.67 ijk ± 0.577 | 18.67 kl ± 0.577 | 19.67 lmn ± 0.577 |
| PGT17 | 19.67 lmn ± 0.577 | 17.00 hi ± 0.000 | 19.33 lm ± 0.577 |
| PGT18 | 17.67 ijk ± 0.577 | 14.67 cd ± 0.577 | 18.33 jk ± 0.577 |
| PGT19 | 19.67 lmn ± 0.577 | 18.33 jk ± 0.577 | 18.00 jk ± 0.000 |
| PGT20 | 19.67 lmn ± o.577 | 18.33 jk ± 0.577 | 19.67 lmn ± 0.577 |
| PGT21 | 17.33 hij ± 0.577 | 18.33 jk ± 0.577 | 18.33 jk ± 0.577 |
| PGT22 | 19.67 lmno ± 0.577 | 21.67 pqr ± 0.577 | 18.33 jk ± 0.577 |
| PGT23 | 18.33 jk ± 0.577 | 19.67 lmno ± 0.577 | 19.67 lmno ± 0.577 |
| PGT24 | 20.67 nop ± 0.577 | 19.67 lmn ± 0.577 | 20.00 mno ± 0.000 |
| PGT25 | 14.00 c ± 0.000 | 21.67 pqr ± 0.577 | 14.67 cd ± 0.577 |
| PGT26 | 12.33 b ± 0.577 | 18.33 jk ± 0.577 | 15.67 ef ± 0.577 |
| PGT27 | 11.00 a ± 0.000 | 18.00 jk ± 0.000 | 15.00 de ± 0.000 |
| PGT28 | 11.00 a ± 0.000 | 18.33 jk ± 0.577 | 15.00 de ± 0.000 |
| PGT29 | 12.33 b ± 0.577 | 17.67 ijk ± 0.577 | 19.67 lmn ± 0.577 |
| PGT30 | 24.67 v ± 0.577 | 24.67 v ± 0.577 | 20.67 nop ± 0.577 |
| PGT31 | 22.67 st ± 0.577 | 23.67 u ± 0.577 | 21.00 opq ± 0.000 |
| PGT32 | 24.67 v ± 0.577 | 25.00 v ± 0.000 | 21.67 pqr ± 0.577 |
| PGT33 | 22.67 st ± 0.577 | 25.33 v ± 0.577 | 23.00 uv ± 0.000 |
| PGT34 | 21.00 opq ± 0.000 | 21.67 pqr ± 0.577 | 19.67 lmno ± 0.577 |
| PGT35 | 22.67 st ± 0.577 | 20.00 mn ± 0.000 | 20.67 nop ± 0.000 |
| Positive | 25.00 v ± 0.577 | 26.00 v ± 0.000 | 25.00 rs ± 0.000 |
| Negative | 0 a | 0 a | 0 a |
| SL. No. | RT (mins) | Name of the Compound Trichoderma harzianum (PGT4) | Molecular Formula | Molecular Weight |
|---|---|---|---|---|
| 1 | 10.70 | 4-Propylbenzaldehyde | C10H12O | 148 |
| 2 | 13.37 | 6-Pentyl-2H-pyran-2-one | C10H14O2 | 166 |
| 3 | 14.02 | 2,4-Di-tert-butylphenol | C14H22O | 206 |
| 4 | 15.76 | 4,6-O-Furylidene-d-glucopyranose | C11H14O7 | 258 |
| 5 | 16.55 | Trimethyl-3,4-undecadiene-2,10-dione | C14H22O2 | 222 |
| 6 | 17.37 | 1,5-Diphenyl-3-(3-cyclopentylpropyl)pentane | C25H34 | 334 |
| 7 | 18.10 | 1-[2-Methyl-2-(-4-methyl-3-pentenyl)cyclopropyl]ethanol | C12H22O | 182 |
| 8 | 21.44 | Phthalic acid, diisobutyl ester | C16H22O4 | 278 |
| 9 | 22.36 | Dibutyl phthalate | C16H22O4 | 278 |
| 10 | 22.77 | Phthalic acid, butyl 2-pentyl ester | C17H24O4 | 292 |
| 11 | 23.38 | Phthalic acid, 6-ethyl-3-octyl butyl ester | C22H34O4 | 362 |
| 12 | 24.17 | Dibutyl phthalate | C16H22O4 | 278 |
| 13 | 31.79 | 3-Ethyl-3-hydroxyandrostan-17-one | C21H34O2 | 318 |
| 14 | 32.44 | Mono(2-ethylhexyl) phthalate | C16H22O4 | 278 |
| 15 | 35.87 | Digitoxin | C41H64O13 | 764 |
| SL. No. | RT (mins) | Name of the Compound Trichoderma reesei (PGT5) | Molecular Formula | Molecular Weight |
|---|---|---|---|---|
| 1 | 8.02 | n-Nonaldehyde | C9H18O | 142 |
| 2 | 10.82 | p-propylbenzaldehyde | C10H12O | 148 |
| 3 | 12.95 | 4-(2-Hydroxyethyl)phenol | C8H10O2 | 138 |
| 4 | 14.13 | Phenol, 2,4-di-tert-butyl | C14H22O | 206 |
| 5 | 19.14 | (3E)-3-Octadecene | C18H36 | 252 |
| 6 | 20.65 | Phthalic acid, butyl isobutyl ester | C16H22O4 | 278 |
| 7 | 22.52 | Dibutyl phthalate | C16H22O4 | 278 |
| 8 | 22.93 | Phthalic acid, butyl 2-pentyl ester | C17H24O4 | 292 |
| 9 | 23.54 | 1,2-Benzenecarboxylic acid, bis(2-methylpropyl) ester | C16H22O4 | 278 |
| 10 | 24.34 | Dibutyl phthalate | C16H22O4 | 278 |
| 11 | 27.11 | 1-Hydroxy-4-methylanthra-9,10-quinone | C15H10O3 | 238 |
| 12 | 28.82 | 3-Chloro-6-(phenylsulfsnyl)bicycle(3.1.1)hept-2-ene | C13H13CIS | 236 |
| 13 | 32.57 | Mono(2-ethylhexyl) phthalate | C16H22O4 | 278 |
| 14 | 33.27 | (10E)-10-Henicosene | C21H42 | 294 |
| 15 | 21.59 | Phthalic acid, diisobutyl ester | C16H22O4 | 278 |
| SL. No. | RT (mins) | Name of the Compound Trichoderma reesei (PGT13) | Molecular Formula | Molecular Weight |
|---|---|---|---|---|
| 1 | 7.93 | 5,6-Dimethylundecane | C13H28 | 184 |
| 2 | 9.36 | 1-Methylene-1H-indene | C10H8 | 128 |
| 3 | 10.72 | Benzaldehyde, 4-propyl | C10H12O | 148 |
| 4 | 14.03 | Phenol, 2,4-di-tert-butyl | C14H22O | 206 |
| 5 | 14.35 | Maleic acid, dibutyl ester | C12H20O4 | 228 |
| 6 | 15.31 | Phthalic acid, ethyl 2-methylbutyl ester | C15H20O4 | 264 |
| 7 | 19.65 | Tetradeconic acid, 1-methylethyl ester | C17H32O2 | 270 |
| 8 | 21.44 | Phthalic acid, butyl isobutyl ester | C16H22O4 | 278 |
| 9 | 22.34 | Dibutyl phthalate | C16H22O4 | 278 |
| 10 | 22.77 | Phthalic acid, butyl 2-pentyl ester | C17H24O4 | 292 |
| 11 | 24.15 | Phthalic acid, butyl hexyl ester | C18H6O4 | 306 |
| 12 | 26.92 | Anthraquinone, 1-hydroxy-2-methyl | C15H10O3 | 238 |
| 13 | 30.73 | Cis-4,7,10,13,16,19-Docosahexanoic acid, tert-butyldimethyldilyl ester | C28H46O2Si | 442 |
| 14 | 32.46 | 9-t-Butyltricyclo[4.2.1.1(2,5)]decane-9-10-diol | C14H24O2 | 224 |
| 15 | 36.62 | (5E,7E)-25-[(Trimethylsilyl)oxy]-9, 10-secocholesta-5,7,10-triene-1,3-diol | C30H52O3Si | 488 |
| 16 | 38.21 | 2,6-Ditert-butyl-4-methylphenyl 2-methylcyclopropanecarboxylate | C20H30O2 | 302 |
| SL. No. | RT (mins) | Name of the Compound Sample A (4,5,13) | Molecular Formula | Molecular Weight |
|---|---|---|---|---|
| 1 | 10.71 | Benzaldehyde, 4-propyl | C10H12O | 148 |
| 2 | 18.11 | 1-[2-Methyl-2-(-4-methyl-3-pentenyl)cyclopropyl]ethanol | C12H22O | 182 |
| 3 | 5.79 | 4-Hydroxybenzenephophoric acid | C6H7O4P | 174 |
| 4 | 7.94 | Nonanal | C9H18O | 142 |
| 5 | 14.03 | Phenol, 2,4,-di-tert-butyl | C14H22O | 206 |
| 6 | 21.55 | 1-Oxa-spiro[4,5]deca-6,9-diene-2,8-dione, 7,9-di-tert-butyl | C17H24O3 | 276 |
| 7 | 22.28 | Hexadecanoic acid | C16H32O2 | 256 |
| 8 | 23.91 | Chrysophanic acid anthranol | C15H12O3 | 240 |
| 9 | 25.58 | Trans-13-Octadecenoic acid | C18H34O2 | 282 |
| 10 | 26.95 | 1-Hydroxy-4-methylanthra-9, 10-quinone | C15H10O3 | 238 |
| 11 | 29.29 | 10,12-Pentacosadiynoic acid | C25H42O2 | 374 |
| 12 | 30.35 | 4-(2-Oxiranyl)-9H-fluoren-9-ol | C15H12O2 | 224 |
| 13 | 32.47 | 9-t-Butyltricyclo[4.2.1.1(2,5)]decane-9,10-diol | C14H24O2 | 224 |
| 14 | 33.14 | 6,9-Octadecadiynoic acid, methyl ester | C19H30O2 | 290 |
| 15 | 36.61 | Ledene oxide-(II) | C15H24O | 220 |
| SL. No. | Trichoderma spp. Coculture Secondary Metabolite | Xoo Isolates (Zone of Inhibition) | ||
|---|---|---|---|---|
| MBXoo69 (8SB) (mm in Diameter) | MBXoo70 (9SB) (mm in Diameter) | MBXoo53 (21) (mm in Diameter) | ||
| 1 | PGT13 | 24 defgh ± 1.00 | 25.33 gh ± 1.15 | 24.67 fgh ± 0.577 |
| 2 | PGT4,5,13 | 22.33 cde ± 1.528 | 28 i ± 1.00 | 21.67 cd ± 1.528 |
| 3 | PGT4,13 | 22 cd ± 2.000 | 24.67 gh ± 0.577 | 22.00 cd ± 1.000 |
| 4 | PGT4 | 15.67 b ± 1.155 | 15.67 b ± 1.155 | 13.33 a ± 1.528 |
| 5 | PGT5 | 20.33 c ± 0.577 | 23.33 def ± 1.155 | 24.33 efg ± 0.577 |
| 6 | PGT5,13 | 20.67 c ± 0577 | 23.33 def ± 1.528 | 21.67 cd ± 1.528 |
| 7 | PGT4,5 | 21.67 cd ± 0.577 | 21.67 cd ± 0.577 | 20.67 c ± 0.577 |
| Positive | Positive | 26.00 gh ± 1.732 | 29.33 hi ± 1.155 | 27.67 i ± 0.577 |
| Negative | Negative | 0 a | 0 a | 0 a |
| ZnO NPs | Disc Diffusion Values (in mm) | MIC Values (µg/mL) |
|---|---|---|
| PGT 4 | 00 | 50 |
| PGT5 | 14.33 ± 0.33 | 25 |
| PGT13 | 00 | 50 |
| PGTA | 15.67 ± 0.33 | 25 |
| Positive | 13.67 ± 0.33 | 25 |
| Negative | 00 | 00 |
© 2020 by the authors. Licensee MDPI, Basel, Switzerland. This article is an open access article distributed under the terms and conditions of the Creative Commons Attribution (CC BY) license (http://creativecommons.org/licenses/by/4.0/).
Share and Cite
Shobha, B.; Lakshmeesha, T.R.; Ansari, M.A.; Almatroudi, A.; Alzohairy, M.A.; Basavaraju, S.; Alurappa, R.; Niranjana, S.R.; Chowdappa, S. Mycosynthesis of ZnO Nanoparticles Using Trichoderma spp. Isolated from Rhizosphere Soils and Its Synergistic Antibacterial Effect against Xanthomonas oryzae pv. oryzae. J. Fungi 2020, 6, 181. https://doi.org/10.3390/jof6030181
Shobha B, Lakshmeesha TR, Ansari MA, Almatroudi A, Alzohairy MA, Basavaraju S, Alurappa R, Niranjana SR, Chowdappa S. Mycosynthesis of ZnO Nanoparticles Using Trichoderma spp. Isolated from Rhizosphere Soils and Its Synergistic Antibacterial Effect against Xanthomonas oryzae pv. oryzae. Journal of Fungi. 2020; 6(3):181. https://doi.org/10.3390/jof6030181
Chicago/Turabian StyleShobha, Balagangadharaswamy, Thimappa Ramachandrappa Lakshmeesha, Mohammad Azam Ansari, Ahmad Almatroudi, Mohammad A. Alzohairy, Sumanth Basavaraju, Ramesha Alurappa, Siddapura Ramachandrappa Niranjana, and Srinivas Chowdappa. 2020. "Mycosynthesis of ZnO Nanoparticles Using Trichoderma spp. Isolated from Rhizosphere Soils and Its Synergistic Antibacterial Effect against Xanthomonas oryzae pv. oryzae" Journal of Fungi 6, no. 3: 181. https://doi.org/10.3390/jof6030181
APA StyleShobha, B., Lakshmeesha, T. R., Ansari, M. A., Almatroudi, A., Alzohairy, M. A., Basavaraju, S., Alurappa, R., Niranjana, S. R., & Chowdappa, S. (2020). Mycosynthesis of ZnO Nanoparticles Using Trichoderma spp. Isolated from Rhizosphere Soils and Its Synergistic Antibacterial Effect against Xanthomonas oryzae pv. oryzae. Journal of Fungi, 6(3), 181. https://doi.org/10.3390/jof6030181

